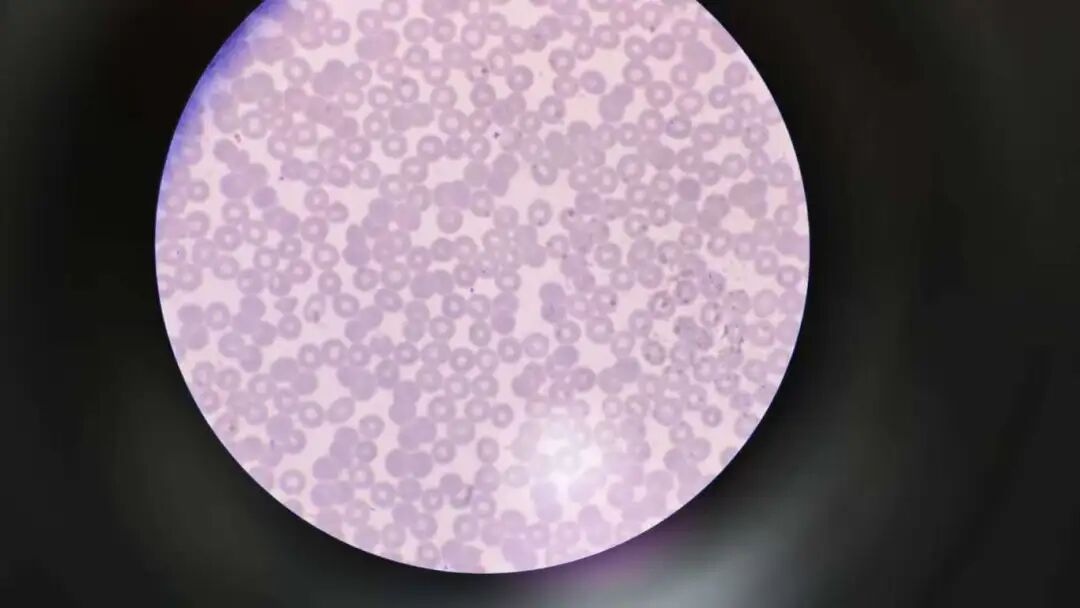

医疗
-

“体医融合”助力中国足球青训体系升级
在中国足球改革深入推进、青少年体育人才培养备受关注的当下,一场跨越体育与医疗领域的战略合作正式启航。近日,第三附属医院与恒大足球学校在广州举行签约授牌仪式,双方将共同打造“体医融合”新范式,为青少年足球人才构筑全方位的健康保障体系。筑牢青训健康基石,响应足球强国战略作为中国足球青训领域的标杆,恒大足球学校建校十余年来,其人才培养质量与规模在国内首屈一指。然…
-

在离天空最近的地方铸造钢铁脊梁——程亮获2025年广东省“民族团结进步模范个人”
近日,在广州市召开的全省民族团结进步表彰大会上,第三附属医院脊柱外科副主任医师程亮荣获2025年广东省“民族团结进步模范个人”称号。这位从医13年屡获"羊城好医生"称号的骨科专家,用300余例高难度脊柱微创手术,使林芝市脊柱内镜技术水平跃居自治区领先、国内先进行列;以"造血式"援藏模式打造带不走的医疗队,更深入牧区开展"共筑脊梁"公益行动,让10余名藏族青少年重获挺拔身姿…
-

他用银针叩响无声世界,古方破解鼻咽阴霾,为耳鼻喉患者带来希望
周小军,中西医结合医院耳鼻喉科主任、五官医学中心负责人、主任医师、博士生导师。在诊室里,周小军轻轻捻动一支75毫米长的银针,针尖缓缓探入患者面部的下关穴深处。一位因突发性耳聋几乎丧失听力的年轻人,在数次治疗后,听力表上的数字悄然回升,几乎重返正常——这不仅是技术的胜利,更是周小军多年来在中西医结合耳鼻喉领域深耕的缩影。理论融合:从“气血耳窍”到神经刺激,打通…
-
援非手记|我在比奥科岛的第一例急诊
九月的一个上午,我在马拉博驻地接诊了一名重症患者。当时他在几位工友的搀扶下,跌跌撞撞地来到中国医疗队的马拉博驻地门诊求医。这位患者当时的情况十分危急,整个人虚弱得几乎无法独立行走。我刚好在门诊整理门诊用物,见状当即放下手头工作,进行接诊通过细致耐心的问诊。驻地来了一名高烧的重症患者患者已经反复出现高烧(超过39℃)有3天时间了,在发热之前会全身发冷、打哆嗦,…
-

这场急诊远程单孔机器人急腹症手术,让优质医疗触手可及
近日,一场跨越院区的急诊远程“云端手术”顺利完成:南方医院普通外科主任胡彦锋团队远程操控单孔手术机器人,成功为增城院区常见高发急腹症的患者完成胃肠精准手术。这不仅是增城院区首例远程单孔机器人手术,更在华南地区开创了腹部急诊单孔机器人手术的先河,标志着院区在精准医疗与智慧技术融合领域迈出关键一步。当天上午8时,南方医院本部手术控制中心内,胡彦锋紧盯高清3D显示…










